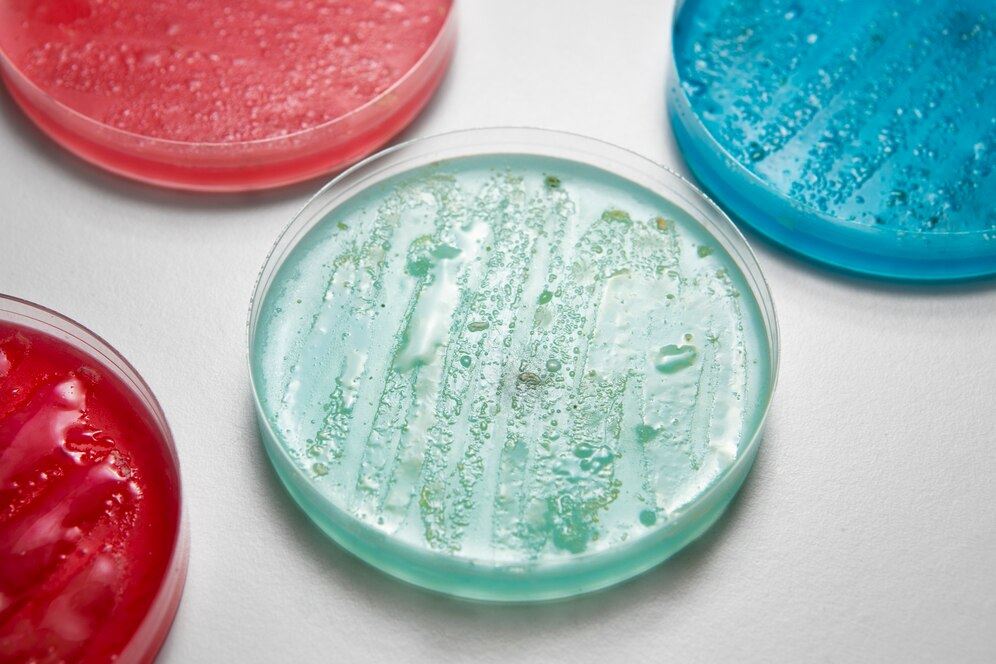
MIB-CM<sup>®</sup> Dry Power Medium

MIB-CM® Dry Power Medium
Distributed under Freepik License, from Freepik.
Distributed under Freepik License, from Freepik.
Classical Cell Culture media are essential for microbiology research. Based on our diligent attention to detail in manufacturing, Creative Biolabs provides a series of novel MIB-CM® dry powder media for our customs all over the world.
Compared with liquid medium, our dry powder media present great advantages, such as cost savings, longer shelf life, and easy to transport.
Product List:
MIB-CM® Vogel-Johnson Agar Medium
Cat: DPM001 Price: $120
Size: 250g
Description: a medium for selective separation and cultivation of S. aureus in medicine.
MIB-CM® Baird-Parker Agar Medium
Cat: DPM002 Price: $120
Size: 250g
Description: a selective medium for the detection and enumeration of coagulase-positive staphylococci from food samples.
MIB-CM® Brilliant Green-Agar Medium
Cat: DPM003 Price: $120
Size: 250g
Description: a highly selective medium used for the isolation of salmonellae other than S. Typhi from feces and other clinical specimens.
MIB-CM® Selenite Cystine Broth
Cat: DPM004 Price: $ 80
Size: 100g
Description: a selective enrichment medium for the isolation of Salmonella from feces, foods, pharmaceutical articles, water and other materials.
MIB-CM® SoyaBean Casein Digest Agar
Cat: DPM005 Price: $120
Size: 250g
Description: a general-purpose medium used for cultivation of a wide variety of microorganisms from clinical and non-clinical samples and for sterility testing in pharmaceutical procedures.
MIB-CM® Sabouraud's Agar
Cat: DPM006 Price: $120
Size: 250g
Description: a selective medium for the cultivation and differentiation of fungi.
MIB-CM® Thioglycollate Medium
Cat: DPM007 Price: $120
Size: 250g
Description: the medium to determine the oxygen requirements of microorganisms and used to cultivate aerobic bacteria, anaerobic bacteria and sterility test.
MIB-CM® Pyocyanin Test Medium
Cat: DPM008 Price: $120
Size: 250g
Description: the medium used for pyocyanin determination test for P. aeruginosa.
MIB-CM® MacConkey Agar Medium
Cat: DPM009 Price: $120
Size: 250g
Description: the selective medium used for the isolation and differentiation of non-fastidious gram-negative rods, particularly members of the family Enterobacteriaceae and the genus Pseudomonas.
MIB-CM® Violet Red Bile Glucose Agar
Cat: DPM010 Price: $120
Size: 250g
Description: a glucose-containing selective medium for the detection and enumeration of Enterobacteriaceae.
MIB-CM® Trypticase Soy Agar Medium
Cat: DPM011 Price: $120
Size: 250g
Description: a general-purpose culture medium for cultivation, isolation of fastidious or nonfastidious microorganisms or for maintenance of stock culture.
MIB-CM® Rose Bengal Agar Medium
Cat: DPM012 Price: $120
Size: 250g
Description: a selective medium to detect and enumerate yeasts and moulds in food samples.
MIB-CM® 1% Tween80-Corn Agar Medium
Cat: DPM013 Price: $120
Size: 100g
Description: the medium used for cultivating candida albicans.
MIB-CM® Eosin Methylene Blue Agar
Cat: DPM014 Price: $120
Size: 250g
Description: a differential microbiological medium, which slightly inhibits the growth of Gram-positive bacteria and provides a color indicator.
MIB-CM® Nutrient Agar
Cat: DPM015 Price: $120
Size: 250g
Description: a general purpose, nutrient medium used for the cultivation of microbes supporting growth of a wide range of non-fastidious organisms.
MIB-CM® Columbia Blood Agar Base
Cat: DPM016 Price: $120
Size: 250g
Description: a multi-purpose medium suitable for the cultivation of fastidious organisms.
MIB-CM® Triple Sugar Iron Agar
Cat: DPM017 Price: $120
Size: 250g
Description: a medium used for biochemical reaction screening of Enterobacteriaceae bacteria.
If you are interested in the listed products, please do not hesitate to inquire us for a quote.
For Research Use Only.
